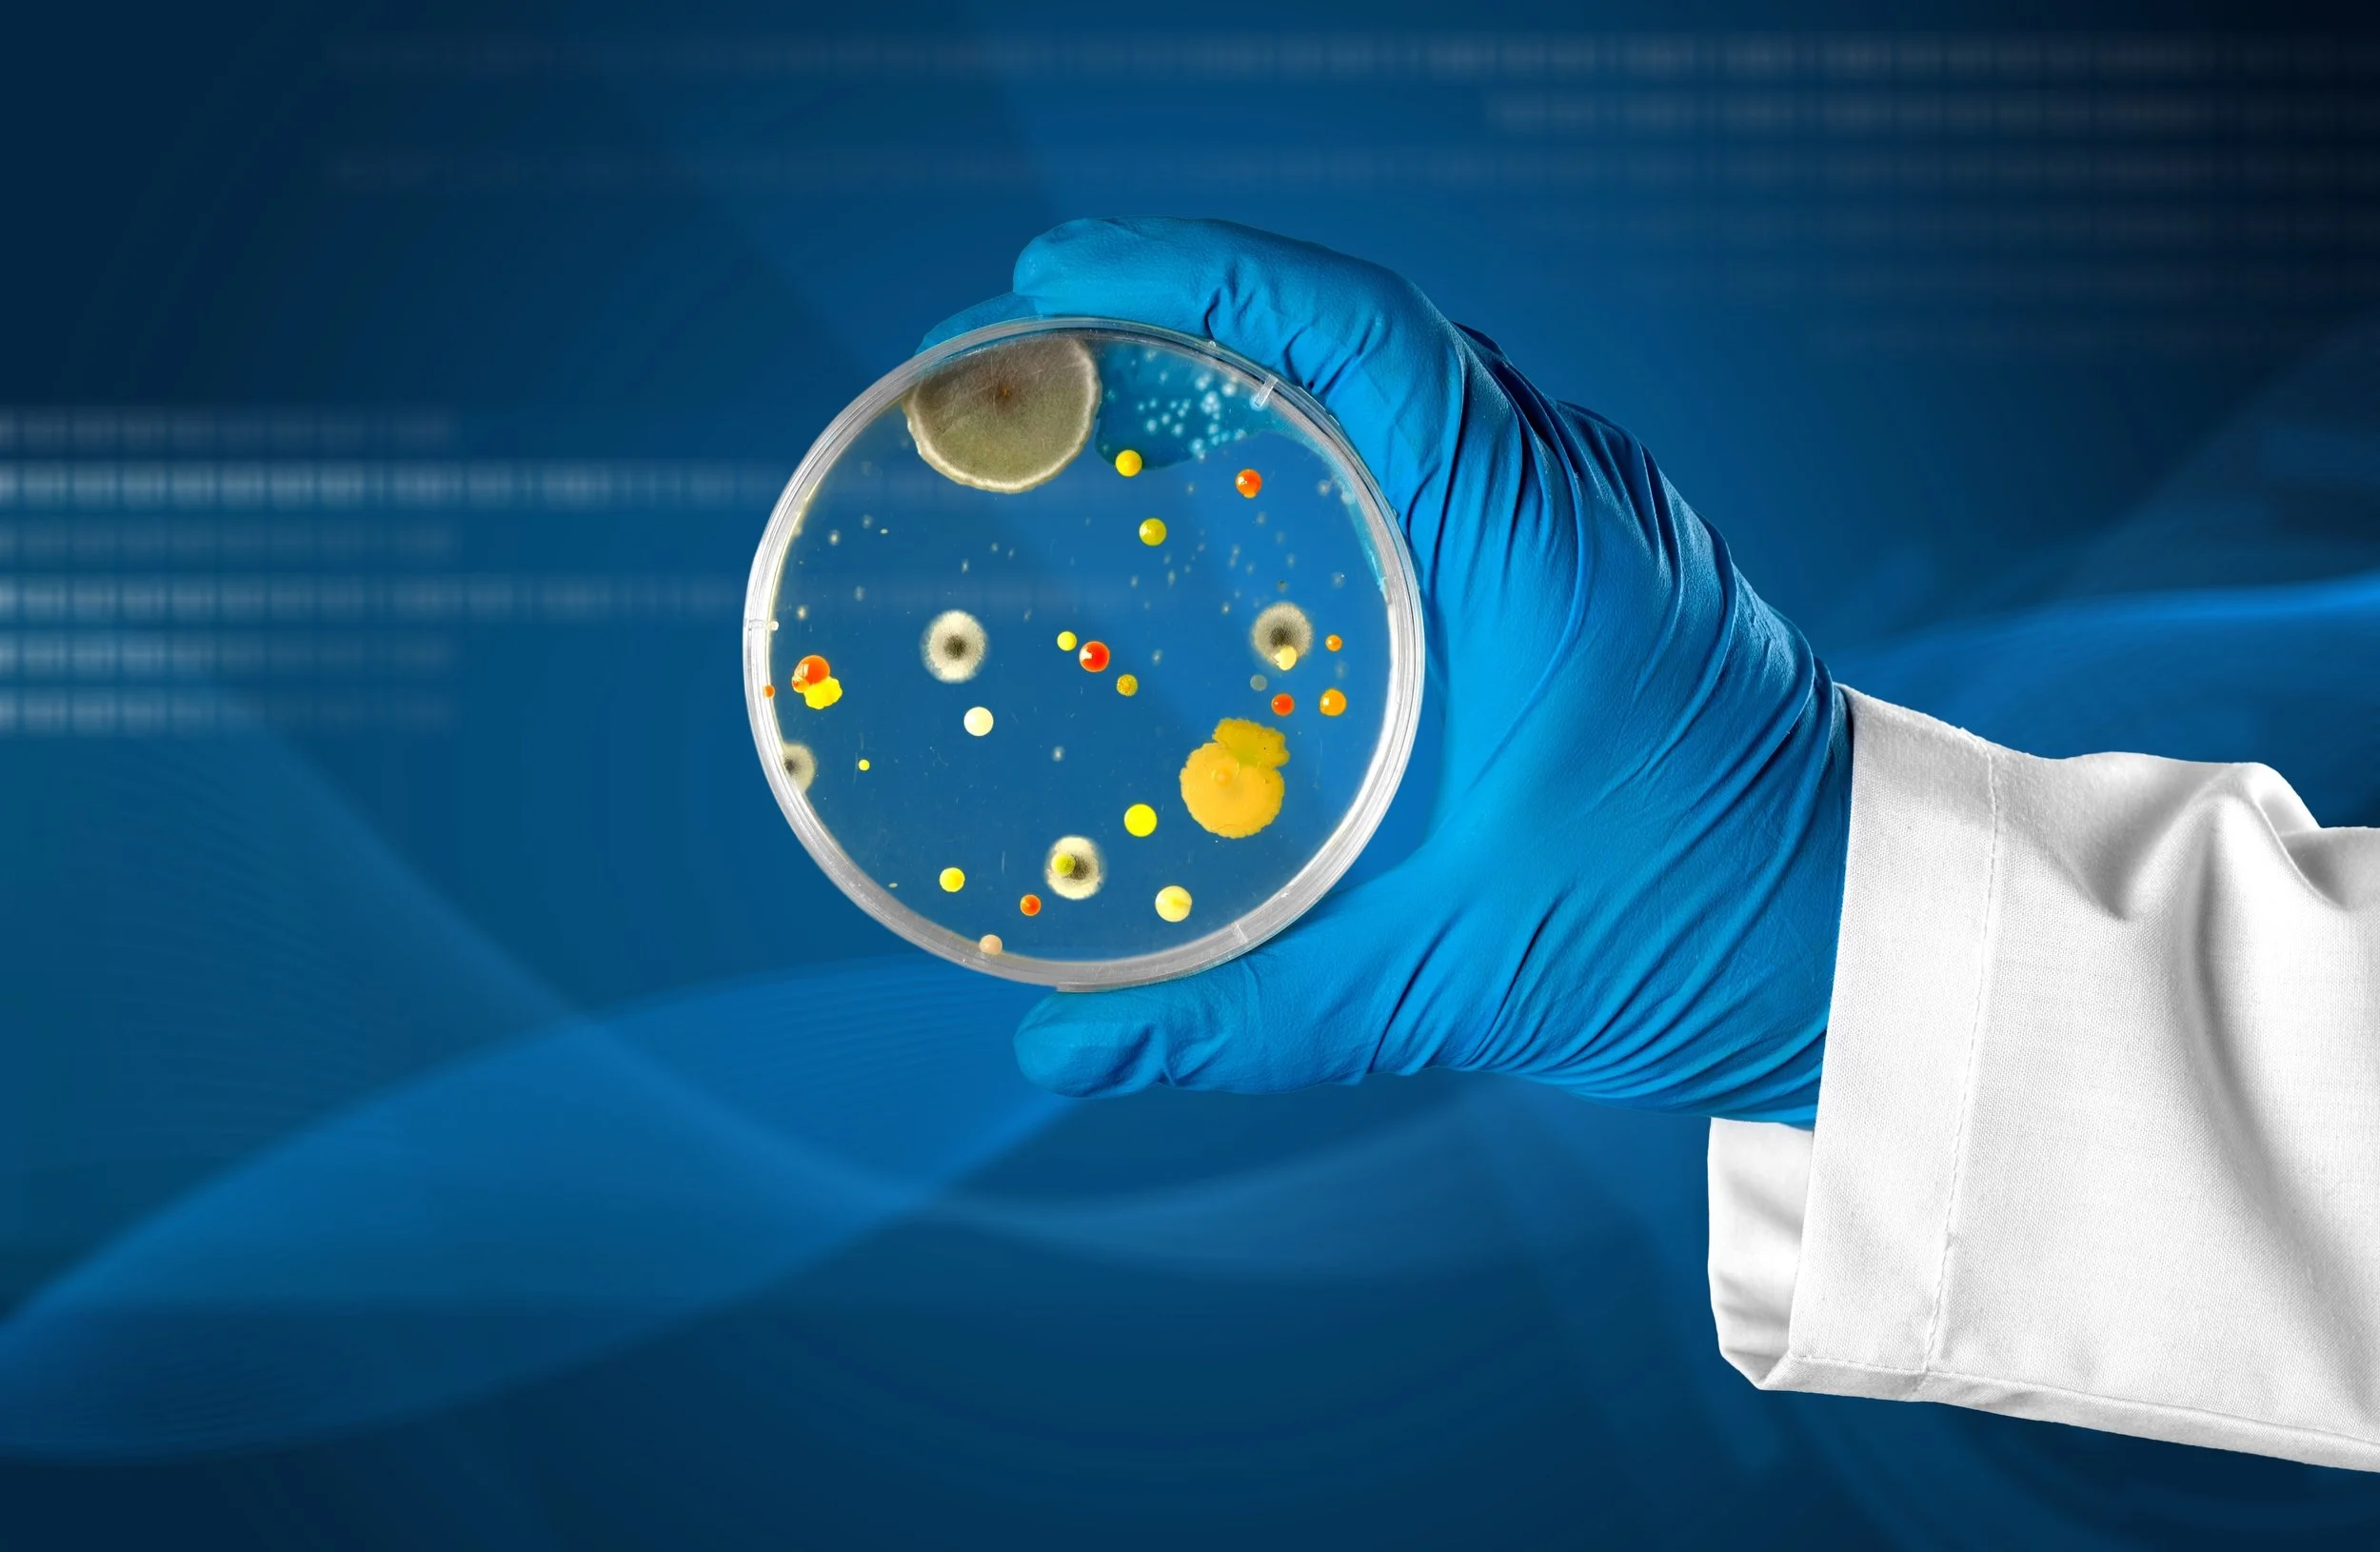

Independent Science
Because we care
Discover peace of mind and get science on your side with Mycotec.
Our certified inspectors use cutting-edge microbiology to expose hidden dangers that could harm your family's health.
-
![A hand holding a blue air bubble shiny and angelic with the word air quality inside it]()
Indoor Air Quality Inspections
Expert home inspections, testing Mould, Bacteria, Volatile Organic Compounds, Fire Damage, Asbestos, Lead & More.
-
![]()
Air Conditioner Inspections
Ducted, Split & HVAC System inspections
-
![]()
On-Site Microscopy
24 / 7 access to an on-site expert authority, real time results, recommendations, and expedition of your project timeline
-
![Viable Air Mould plates, Penicillium, Bacteria, Blue Mould]()
Mycology / Mould
What is Mycology? The Health Risks, Science, and Expert Advice you need to make informed decisions.
-
![]()
Flooding & Water Damage Inspections
Flood Waters contain Bacteria and viruses and can contribute to the growth of mould in affected houses
-
![Ash from a fire]()
Fire Inspections
Air and surface sampling of fire and smoke damaged buildings to determine the cause, and level of danger to occupants.
-
![Project Manager working on laptop with statistics and charts]()
Project Management
Overseeing every step of the remediation process to ensure the highest standard of efficiency, and quality of detail in restoration.
-
![Scientist Testing with Microscope and petri dish, blue liquid, safety goggles]()
Product Testing
Rigorous & Independent Scientific testing of product efficacy to ensure the constant improvement of industry standards & services
-
![]()
Expert Witnessing
Independent expert witness reporting is invaluable in legal disputes with high stakes, distorted facts, unjust rulings, and emotional turmoil.
-
![]()
Laboratory Services
Expert Analysis of Mould, Bacteria, Soot, Ash, Char, Asbestos, Lead, Diseases & More
-
![]()
Types of Inspection
There are three main types of Independent assessment, a Pre-Inspection, PRV and Clearance Test.